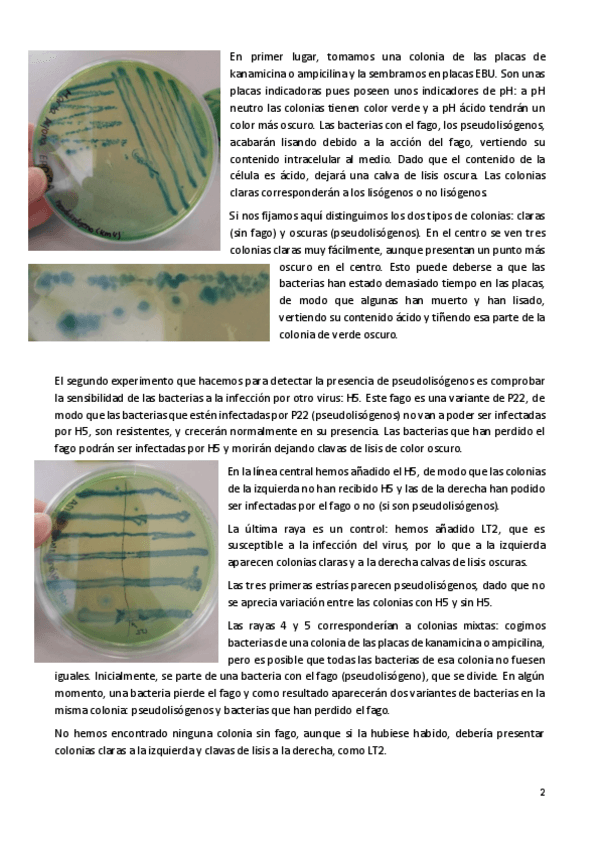

@M_Biotec
68 Publicaciones
4.16k Interacciones
0 Seguidores
0 Siguiendo
Lista de publicaciones de M_Biotec
ejercicios
-
Problemas y ejemplos resueltos
He publicado nuevos ejercicios de 3º Biorreactores: Problemas y ejemplos resueltos
apuntes
-
Apuntes completos
He publicado nuevos apuntes de 4º Química e Ingeniería de Proteínas: Apuntes completos
He publicado nuevos practicas de 4º Química e Ingeniería de Proteínas: Cuestiones-EPD-1-y-2.pdf
He publicado nuevos practicas de 4º Aspectos Éticos y Legales de la Biotecnología: EPD-1-Legal.pdf
He publicado nuevos practicas de 4º Aspectos Éticos y Legales de la Biotecnología: EPD-2-Legal.pdf
He publicado nuevos apuntes de 4º Procesos Biotecnológicos: 15.-Biorremediacion.pdf
He publicado nuevos apuntes de 4º Procesos Biotecnológicos: 13.-BIOENERGIA.pdf
He publicado nuevos apuntes de 4º Procesos Biotecnológicos: 14.-Biodegradacion.pdf
He publicado nuevos apuntes de 4º Inmunología: Tema-12.-Inmunidad-y-tumores.pdf
He publicado nuevos apuntes de 4º Inmunología: Tema-11.-Inmunologia-del-transplante.pdf
apuntes
-
Ejercicios y problemas propuestos
He publicado nuevos apuntes de 2º Fundamentos de Ingeniería Bioquímica: Ejercicios y problemas propuestos
apuntes
-
Prácticas
He publicado nuevos apuntes de 4º Química Bioanalítica: Prácticas
He publicado nuevos apuntes de 2º Genética Molecular: Genetica-Molecular-Temas-3-4-Regulacion-de-la-traduccion.pdf
apuntes
-
Apuntes por temas
He publicado nuevos apuntes de 4º Química Bioanalítica: Apuntes por temas